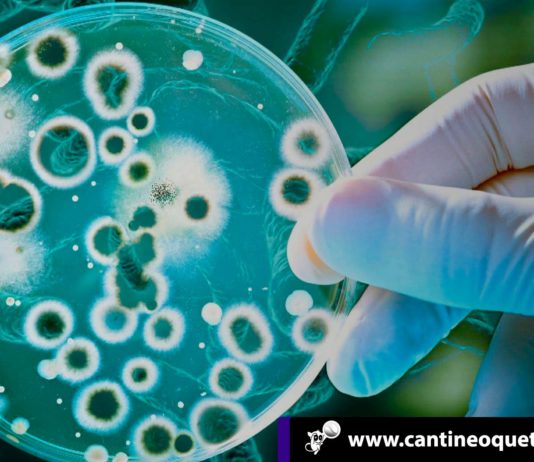
La guerra de los mundos o nuestra alianza con las bacterias Las bacterias - Cantineoqueteveonews

¡En hora buena! Conoce estos 7 tips para aumentar tu autoestima en un mes
Se puede decir que el autoestima es la percepción que tenemos de nosotros mismos. Abarca todos los aspectos de la vida, desde el físico hasta el interior y se trata de la valoración que...
Cómo el algoritmo desarrollado por Blue Dot predijo el coronavirus
El algoritmo desarrollado por Blue Dot carece de la atractiva aura misteriosa de Nostradamus. Su libro Les Propheties (Las Profecías), publicado en 1555 ha sido la referencia obligada para todas las catástrofes sufridas. Los seguidores...
Tomar infusiones para cada momento del día !Descubre los beneficios!
Tomar infusiones puede convertirse en los mejores aliados para estimularnos, reducir molestias estomacales o conciliar el sueño. Las infusiones esconden beneficios para el organismo, son totalmente naturales, ayudan a eliminar toxinas; activan la circulación, tienen...
Mujeres: ¡Nuestro cuerpo es mágico! Senos en forma de flor
En los últimos días en las redes sociales se hizo viral una imagen del sistema muscular femenino; las personas no pueden creer cómo se ven; en la imagen se aprecian los ductos en forma...
Descubre cómo elegir la base de maquillaje según el tipo de piel
A veces elegir la base de maquillaje correcta para la piel no es fácil
Nos ha pasado alguna vez que hemos elegido una base de maquillaje con una cobertura que crea un efecto mascara; o...
Trucos de la cuchara en el maquillaje ¡No te lo pierdas!
Pues así como lo lees, a veces no sabemos que las mejores herramientas para aplicar nuestro maquillaje son las más sencillas y que tenemos al alcance de la mano. ¿Sabías de los trucos de...
¿Cuáles son los factores que causan la piel seca? ¡Entérate!
¿Eres de esas personas que googlean todos los días “Piel seca” para encontrar algunos remedios para evitar este problema? Pues no eres la única, esta búsqueda se ha incrementado a un 100% de 2010...
Coloca en práctica estos 8 consejos para seguir una dieta balanceada
Los hábitos saludables y una dieta balanceada, son todas aquellas conductas que tenemos capacitadas, como propias en nuestra vida cotidiana y que inciden positivamente en nuestro bienestar físico, mental y social. Tener una dieta incorrecta,...
Pacientes asintomáticos con coronavirus desatan un misterio
Mientras el mundo intenta evitar la propagación del coronavirus, muchos pacientes asintomáticos andan por ahí como si nada. Se trata de un verdadero misterio y aunque hasta la fecha no hay datos concluyentes, se estima...
Reino Unido retira a Portugal del corredor verde de Covid-19
El gobierno británico retiró hoy a Portugal de la lista de países cuyos viajeros están exentos de autoaislamiento o cuarentena hotelera al ingresar al Reino Unido, tras aumentar los casos de Covid-19 en la...